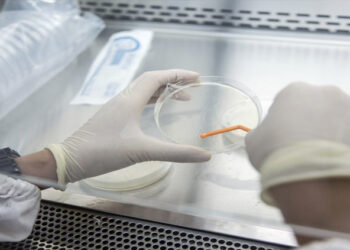
കോവിഡ് മഹാമാരിയേക്കാൾ 20 മടങ്ങ് മാരകം, 406 പേർ ചികിത്സ തേടി,143 മരണം; ഡീസീസ് എക്‌സിനെ കുറിച്ച് കൂടുതൽ

World
പ്രകൃതിദുരന്തങ്ങളിൽ രക്ഷകനായി ഇനി സ്മാര്ട്ട് ഫോണുകളും; നിര്ണ്ണായക സാങ്കേതികവിദ്യയെ കുറിച്ച് കൂടുതൽ അറിഞ്ഞിരിക്കാം
ഇനി സ്മാര്ട്ട് ഫോണുകളിലൂടെ പ്രകൃതിദുരന്തങ്ങളെ മുന്കൂട്ടി അറിയാം . ഇതിനായി വിദഗ്ധര് എഐ നിയന്ത്രിക്കുന്ന തരത്തിലുള്ള ഒരു പുതിയ സംവിധാനത്തിന് രൂപം നല്കി കഴിഞ്ഞു . സ്മാര്ട്ട്...
Read moreDetailsസ്വകാര്യ ഫോട്ടോകളും വീഡിയോകളും ഫോണുകളില് സൂക്ഷിക്കരുത്; നിര്ദ്ദേശങ്ങളുമായി അബുദാബി ജുഡീഷ്യല് ഡിപ്പാര്ട്ട്മെന്റ്
അബുദാബി: സൈബര് സുരക്ഷ ഉറപ്പാക്കാന് മാര്ഗ്ഗനിര്ദ്ദേശങ്ങളുമായി അബുദാബി. സ്വകാര്യ ഫോട്ടോകള്, വീഡിയോകള് തുടങ്ങിയവ സ്മാര്ട്ട് ഫോണുകളില് സൂക്ഷിക്കുന്നത് ഒഴിവാക്കണമെന്ന മുന്നറിയിപ്പാണ് പ്രധാനമായും അബുദാബി ജുഡീഷ്യല് ഡിപ്പാര്ട്ട്മെന്റ് പുറപ്പെടുവിച്ചിരിക്കുന്നത്....
Read moreDetailsഇൻസ്റ്റാഗ്രാം, ഫേസ്ബുക്ക്, വാട്ട്സ്ആപ്പ്, ത്രെഡ് പ്ലാറ്റ്ഫോമുകൾ ലോകവ്യാപകമായി തടസ്സം നേരിടുന്നു; സേർവറുകൾ തകരാറിൽ
മെറ്റയുടെ ഇൻസ്റ്റാഗ്രാം, ഫേസ്ബുക്ക്, വാട്ട്സ്ആപ്പ്, ത്രെഡ് എന്നീ പ്ലാറ്റ്ഫോമുകളുടെ സേർവറുകൾ ലോകവ്യാപകമായി തകരാറിൽ . സന്ദേശം, പോസ്റ്റ്, അപ്ഡേറ്റ്സ് എന്നിവ ഒന്നുകിൽ മന്ദഗതിയിലോ അല്ലെങ്കിൽ പൂർണ്ണമായും ലഭ്യമല്ലാത്ത...
Read moreDetailsകോവിഡ് മഹാമാരിയേക്കാൾ 20 മടങ്ങ് മാരകം, 406 പേർ ചികിത്സ തേടി,143 മരണം; ഡീസീസ് എക്സിനെ കുറിച്ച് കൂടുതൽ
ഒരു അപൂർവ്വ രോഗത്തിന്റെ പിടിയിലമർന്ന് ഡെമോക്രാറ്റിക് റിപ്പബ്ലിക് ഓഫ് കോംഗോ. ഇൻഫ്ളുവൻസയോട് സാമ്യമുള്ള ഈ രോഗം വലിയ തോതിൽ അണുബാധയുള്ളതും മരണനിരക്ക് വർധിപ്പിക്കുന്നതുമായതുകൊണ്ട് ആളുകൾ ഭീതിയാലണെന്നാണ് വിവരം....
Read moreDetailsആഴ്ചയില് 4 ദിവസം മാത്രം ജോലി; ജനസംഖ്യ കൂട്ടാന് കുറുക്കുവഴിതേടി ഈ രാജ്യം
ജനസംഖ്യ നിരക്ക് വര്ധിപ്പിക്കുന്നതിനായി വിവിധ വഴികൾ തേടി ടോക്കിയോ. ഇപ്പോൾ ഇതാ നാല് ദിവസത്തെ നിര്ബന്ധിത വര്ക്ക് വീക്ക് നടപ്പിലാക്കാനൊരുങ്ങി്യിരിക്കുകയാണ് ടോക്കിയോ ഗവണ്മെന്റ്. മെട്രോപൊളിറ്റന് ഗവണ്മെന്റിന്റെ എല്ലാ...
Read moreDetailsസിറിയയിൽ അതിരൂക്ഷ പോരാട്ടം; ആയിരത്തിലധികം ആളുകൾ കൊല്ലപ്പെട്ടു
എമ്മാൻ/ബെയ്റൂട്ട്: സൈന്യവും വിമതരും തമ്മിൽ പോരാട്ടം തുടരുന്ന സിറിയയിൽ മൂന്നുലക്ഷത്തോളം ആളുകൾ പലായനം ചെയ്തതായി ഐക്യരാഷ്ട്ര സഭ. ആയിരക്കണക്കിന് ആളുകളാണ് ഹോംസിൽ നിന്ന് ഒറ്റരാത്രികൊണ്ടാണ് പടിഞ്ഞാറൻ തീരത്തേക്ക്...
Read moreDetailsഇന്ത്യയിലെ നിക്ഷേപം ഏറെ ലാഭകരം; മോദിയെ വാനോളം പുകഴ്ത്തി പുടിൻ
മോസ്കോ/ന്യൂഡൽഹി: നിക്ഷേപം ലാഭകരമായതിനാൽ ഇന്ത്യയിൽ ഉൽപ്പാദന കേന്ദ്രങ്ങൾ സ്ഥാപിക്കാൻ റഷ്യൻ കമ്പനികൾ തയ്യാറാണെന്ന് റഷ്യൻ പ്രസിഡൻ്റ് വ്ളാഡിമിർ പുടിൻ. ‘മെയ്ക്ക് ഇൻ ഇന്ത്യ’ സംരംഭത്തെയും പ്രധാനമന്ത്രി നരേന്ദ്ര...
Read moreDetailsയുഎസിൽ ശക്തമായ ഭൂചലനം; സുനാമി മുന്നറിയിപ്പ് പിൻവലിച്ചു
കാലിഫോർണിയ: അമേരിക്കയിലെ വടക്കൻ കാലിഫോർണിയ തീരത്ത് വൻഭൂചലനം. റിക്ടർ സ്കെയിലിൽ 7.0 തീവ്രത രേഖപ്പെടുത്തിയ ചലനമാണ് അനുഭവപ്പെട്ടത്, ഒറിഗോൺ അതിർത്തിക്കടുത്തുള്ള തീരദേശ ഹംബോൾട്ട് കൗണ്ടിയിലെ നഗരമായ ഫെർണ്ടെയ്ലിൻറെ...
Read moreDetailsപട്ടാളനിയമം പ്രഖ്യാപിച്ച് ആറു മണിക്കൂറിനകം പിൻവലിച്ച് ദക്ഷിണ കൊറിയ
സോൾ: ദക്ഷിണ കൊറിയയിൽ പ്രഖ്യാപിച്ച പട്ടാളനിയമം ആറു മണിക്കൂറിനകം പിൻവലിച്ച് പ്രസിഡന്റ് യൂൻ സുക് യോൽ. പട്ടാളനിയമം പ്രഖ്യാപനത്തിനു പിന്നാലെ രാത്രി സൈന്യം പാർലമെന്റ് വളഞ്ഞിരുന്നു. തുടർന്ന്...
Read moreDetailsബംഗ്ലാദേശിൽ 3 ക്ഷേത്രങ്ങൾക്കു നേരെ ആൾക്കൂട്ട ആക്രമണം: സംഘർഷം അതിരൂക്ഷം
ധാക്ക: സംഘർഷം തുടരുന്ന ബംഗ്ലാദേശിലെ ചത്തോഗ്രമിൽ 3 ഹിന്ദു ക്ഷേത്രങ്ങൾക്കു നേരെ ആൾക്കൂട്ട ആക്രമണം. തുറമുഖ നഗരത്തിലെ ഹരീഷ് ചന്ദ്ര മുൻസെഫ് ലെയ്നിൽ കഴിഞ്ഞദിവസം ഉച്ചയ്ക്ക് രണ്ടരയോടെയാണ്...
Read moreDetails6,91,473 കോടി രൂപ വിലമതിക്കും; ലോകത്തെ ഏറ്റവും വലിയ സ്വർണനിക്ഷേപം കണ്ടെത്തി
ബീജിങ്: ലോകത്തെ ഏറ്റവും വലിയ സ്വർണ നിക്ഷേപം കണ്ടെത്തി. മധ്യ ചൈനയിലാണ് 1,000 മെട്രിക് ടൺ നിലവാരമുള്ള അയിര് അടങ്ങിയ നിക്ഷേപം കണ്ടെത്തിയത്. ഹുനാൻ പ്രവിശ്യയിലെ ജിയോളജിക്കൽ...
Read moreDetailsസ്വന്തം മകളെ 3 വർഷത്തോളം ഡ്രോയറിൽ ഒളിപ്പിച്ചു; അമ്മയ്ക്ക് 7 വർഷം തടവ് ശിക്ഷ
ലണ്ടൻ: അവിഹിത ബന്ധത്തിലുണ്ടായ സ്വന്തം കുഞ്ഞിനെ 3 വർഷത്തോളം ഡ്രോയറിനുള്ളിൽ ഒളിപ്പിച്ച് വളർത്തിയ സ്ത്രീക്ക് 7 വർഷം തടവ് ശിക്ഷ വിധിച്ച് യുകെയിലെ കോടതി. വീടിനുള്ളിൽ നിലവിലുള്ള...
Read moreDetailsഇസ്രയേൽ-ഹിസ്ബുള്ള സംഘർഷത്തിൽ വെടിനിർത്തലിന് ധാരണ
ടെൽ അവീവ്: ലെബനനുമായി വെടിനിർത്തലിന് സമ്മതിച്ച് ഇസ്രായേൽ. 27ന് പ്രാദേശിക സമയം പുലർച്ചെ നാലു മണിമുതൽ വെടിനിർത്തൽ കരാർ പ്രാബല്യത്തിൽ വരും. ഇസ്രായേലിൻ്റെ സുരക്ഷാ മന്ത്രിസഭ ആണ്...
Read moreDetailsനെതന്യാഹു തങ്ങളുടെ രാജ്യത്തേയ്ക്ക് വന്നാൽ അറസ്റ്റ് ചെയ്യും; സൂചന നൽകി ബ്രിട്ടൻ
ഇസ്രയേൽ പ്രധാനമന്ത്രി ബെഞ്ചമിൻ നെതന്യാഹു തങ്ങളുടെ രാജ്യത്തേയ്ക്ക് വന്നാൽ അറസ്റ്റ് ചെയ്യുമെന്ന സൂചന നൽകി ബ്രിട്ടൻ. അന്താരാഷ്ട്ര ക്രിമിനൽ കോടതിയുടെ വാറണ്ട് ഉള്ളതിനാൽ അറസ്റ്റ് പരിഗണിക്കുമെന്നാണ് ബ്രിട്ടൻ...
Read moreDetailsവിമാനത്തിൻറെ വലിപ്പമുള്ള ഛിന്നഗ്രഹം ഭൂമിക്കരികിലേക്ക്; ആശങ്കയോടെ ശാസ്ത്രലോകം
കാലിഫോർണിയ: പല വലിപ്പത്തിലുള്ള ഛിന്നഗ്രഹങ്ങളാണ് ഭൂമിക്കരികിലൂടെ പാഞ്ഞടുക്കുന്നത്. ഇപ്പോഴിതാ ഒരു വിമാനത്തിൻറെ വലിപ്പമുള്ള ഛിന്നഗ്രഹം ഭൂമിക്ക് വളരെ അരികിലെത്തുമെന്ന് മുന്നറിയിപ്പ് നൽകിയിരിക്കുകയാണ് നാസ. ‘2010 ഡബ്ല്യൂസി’ എന്നാണ്...
Read moreDetails